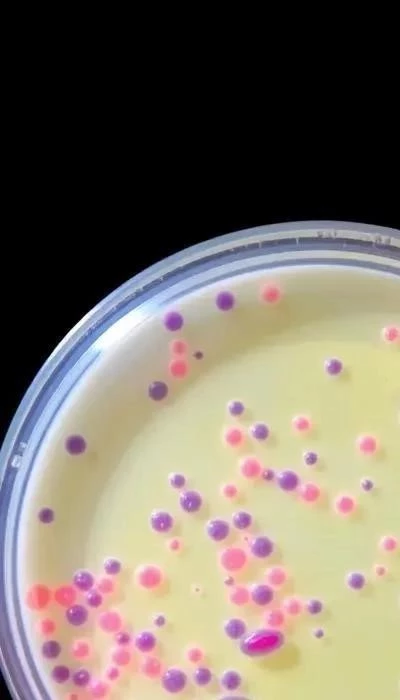

Гонорея – одна из наиболее распространенных инфекций, передающихся половым путем (ИППП). В 2026 году проблема остается актуальной, требуя пристального внимания и своевременного вмешательства. Отсутствие лечения может привести к серьезным осложнениям, включая бесплодие, воспалительные заболевания органов малого таза и распространение инфекции на другие органы. Данная статья предоставит исчерпывающую информацию о симптомах, современных методах диагностики, эффективных подходах к лечению и мерах профилактики гонореи, основываясь на данных, доступных на . Важно помнить, что своевременное обращение к врачу – ключ к успешному лечению и предотвращению негативных последствий. По данным исследований, профилактическое лечение новорожденных, родившихся от матерей с гонококковой инфекцией, остается важной мерой, даже при отсутствии симптомов у ребенка.
Симптомы гонореи могут быть разнообразными и зависят от пола пациента. У мужчин часто наблюдаются жжение и зуд в области мочеиспускательного канала, а также необычные выделения из уретры. Как отмечалось в исследованиях 2019 года, эти симптомы могут сопровождаться дискомфортом при мочеиспускании. У женщин симптомы могут быть менее выражены или вовсе отсутствовать, что затрудняет раннюю диагностику. Возможны выделения из влагалища, жжение при мочеиспускании и боли в области таза. Важно учитывать, что гонорея может поражать не только гениталии, но и другие органы, такие как глаза, горло и суставы, вызывая соответствующие симптомы.
Диагностика гонореи включает лабораторные исследования. Современные методы позволяют быстро и точно выявить возбудителя инфекции. В 2026 году доступны высокочувствительные анализы, позволяющие обнаружить Neisseria gonorrhoeae в различных биологических материалах, включая мазки из уретры, влагалища, горла и прямой кишки. Важно помнить, что самодиагностика недопустима, и при подозрении на гонорею необходимо обратиться к врачу для проведения необходимого обследования.
Актуальность проблемы и цели статьи
Гонорея, известная также как триппер, продолжает оставаться серьезной проблемой общественного здравоохранения в 2026 году. По данным статистики, это одна из наиболее распространенных инфекций, передающихся половым путем (ИППП), оказывающая значительное влияние на репродуктивное здоровье населения. Рост заболеваемости, особенно среди молодежи, требует повышенного внимания и разработки эффективных стратегий профилактики и лечения. Отсутствие своевременной диагностики и адекватной терапии может привести к серьезным осложнениям, таким как воспалительные заболевания органов малого таза у женщин, бесплодие у обоих полов, а также распространение инфекции на другие органы и системы организма.

Актуальность проблемы обусловлена не только высокой распространенностью, но и развитием устойчивости Neisseria gonorrhoeae к антибиотикам, что затрудняет лечение и требует постоянного мониторинга чувствительности возбудителя к препаратам. В связи с этим, разработка новых методов диагностики и лечения, а также повышение осведомленности населения о рисках заражения и мерах профилактики, являются приоритетными задачами в области здравоохранения. Исследования, проведенные в 2026 году, подчеркивают необходимость комплексного подхода к борьбе с гонореей, включающего не только медицинские мероприятия, но и социальные и образовательные программы.
Целью данной статьи является предоставление полной и актуальной информации о гонорее в 2026 году. Мы рассмотрим этиологию, патогенез, клинические проявления, методы диагностики, современные подходы к лечению и эффективные меры профилактики данной инфекции. Статья предназначена для широкого круга читателей, включая медицинских работников, студентов-медиков и всех, кто интересуется вопросами репродуктивного здоровья. Особое внимание будет уделено новым данным и рекомендациям, основанным на последних научных исследованиях и клинической практике. Мы надеемся, что представленная информация поможет читателям лучше понять проблему гонореи и принять обоснованные решения в отношении своего здоровья.
Что такое гонорея?
Гонорея – это инфекционное заболевание, вызываемое бактерией Neisseria gonorrhoeae, также известной как гонококк. Относится к числу инфекций, передающихся половым путем (ИППП), и характеризуется воспалением слизистых оболочек мочеполовых органов, а также может поражать другие системы организма. Альтернативное название гонореи – триппер, исторически использовавшееся для обозначения данного заболевания.
Пути передачи гонореи преимущественно связаны с половым контактом – вагинальным, анальным или оральным. Возможна передача инфекции от матери к ребенку во время родов (вертикальный путь передачи). Гонококк не выживает вне организма человека, поэтому бытовой путь передачи исключен. Поражаемые органы включают уретру, шейку матки, прямую кишку, глотку и глаза. Инфекция может распространяться по кровотоку, вызывая диссеминированные формы гонореи, поражающие суставы, кожу и внутренние органы.
Гонорея считается опасной инфекцией из-за возможности развития серьезных осложнений при отсутствии лечения. У женщин это может привести к воспалительным заболеваниям органов малого таза (ВЗОМТ), бесплодию, внематочной беременности и хроническим тазовым болям. У мужчин гонорея может вызвать эпидидимит, простатит и, в редких случаях, бесплодие. Диссеминированная гонорея может привести к септическому артриту, эндокардиту и менингиту. Важно отметить, что отсутствие лечения может способствовать развитию устойчивости гонококка к антибиотикам, что затрудняет терапию в будущем. Профилактическое лечение новорожденных, родившихся от инфицированных матерей, даже при отсутствии симптомов, является важной мерой предотвращения гонобленнореи.
Симптомы гонореи у мужчин и женщин

Симптомы гонореи значительно различаются у мужчин и женщин. У мужчин наиболее распространенным проявлением является гонорейный уретрит – воспаление мочеиспускательного канала. Характерными признаками являются выделения из уретры (гнойные или серозные), жжение при мочеиспускании и болезненность в области уретры. В некоторых случаях может наблюдаться зуд и дискомфорт в области полового члена. При поражении прямой кишки (гонорейный проктит) возникают боли в области ануса, зуд и выделения из прямой кишки.
У женщин симптомы гонореи часто бывают слабо выражены или вовсе отсутствуют, что затрудняет своевременную диагностику и способствует распространению инфекции. При поражении шейки матки могут наблюдаться выделения из влагалища (слизистые или гнойные), боли в области таза и кровотечения после полового акта. Воспаление слизистых оболочек может приводить к дискомфорту и боли во время полового акта. Важно отметить, что бессимптомное течение гонореи у женщин особенно опасно, так как может привести к развитию воспалительных заболеваний органов малого таза (ВЗОМТ) и бесплодию.
Внегенитальные проявления гонореи также возможны как у мужчин, так и у женщин. Поражение глаз (гонобленнорея) может привести к конъюнктивиту и, в тяжелых случаях, к потере зрения. Гонорея горла (фарингит) проявляется болью в горле, покраснением и отеком слизистой оболочки. В редких случаях гонококк может проникать в суставы, вызывая гонорейный артрит, характеризующийся болью, отеком и ограничением подвижности суставов. Как отмечалось в исследованиях, разнообразие симптомов требует внимательного обследования при подозрении на ИППП.
Диагностика гонореи
Диагностика гонореи является ключевым этапом в борьбе с этой инфекцией. В 2026 году доступны современные и высокоточные методы, позволяющие своевременно выявить возбудителя – Neisseria gonorrhoeae. Основным методом диагностики является лабораторное исследование биологических материалов. Наиболее распространенными являются микроскопическое исследование мазков из уретры (у мужчин), шейки матки (у женщин), горла и прямой кишки. Однако, данный метод имеет ограниченную чувствительность и может давать ложноотрицательные результаты, особенно при бессимптомном течении инфекции.
Более точным и чувствительным методом является культуральное исследование (посев) на питательную среду. Этот метод позволяет выделить чистую культуру возбудителя и определить его чувствительность к антибиотикам. Однако, культуральное исследование требует больше времени (несколько дней) по сравнению с другими методами. В настоящее время широко используются методы полимеразной цепной реакции (ПЦР), которые позволяют обнаружить ДНК Neisseria gonorrhoeae в биологическом материале с высокой чувствительностью и специфичностью. ПЦР-диагностика позволяет получить результаты в течение нескольких часов и является предпочтительным методом диагностики гонореи.
Современная диагностика ЗППП, как подчеркивается в доступных источниках, стремится к быстроте и точности. В 2026 году все больше клиник предлагают комплексные анализы на ЗППП, включающие одновременное определение нескольких инфекций, в том числе гонореи. Важно помнить, что при подозрении на гонорею необходимо обратиться к врачу для проведения полного обследования и получения квалифицированной консультации. Самодиагностика и самолечение недопустимы и могут привести к серьезным осложнениям и развитию устойчивости возбудителя к антибиотикам.
Профилактика гонореи: стратегии защиты в 2026 году
Профилактика гонореи – важнейший аспект борьбы с этой распространенной инфекцией, передающейся половым путем (ИППП). В 2026 году, несмотря на достижения в области лечения, профилактические меры остаются наиболее эффективным способом предотвращения распространения гонококковой инфекции и ее серьезных последствий. Основной стратегией профилактики является безопасный секс, включающий использование презервативов при каждом половом контакте. Презервативы значительно снижают риск передачи гонореи, однако не обеспечивают 100% защиту, поскольку не покрывают все потенциально инфицированные участки тела.
Регулярное обследование на ИППП, особенно для лиц, ведущих активную половую жизнь и имеющих нескольких партнеров, является важной частью профилактики. Раннее выявление и лечение гонореи позволяет предотвратить развитие осложнений и снизить риск передачи инфекции другим людям. Важно помнить, что профилактическое лечение новорожденных, родившихся от матерей с гонореей, остается актуальной мерой, даже при отсутствии симптомов у ребенка, как отмечалось в исследованиях 2026 года. Это позволяет предотвратить гонококковый конъюнктивит и другие серьезные осложнения у новорожденных.
Отказ от случайных половых связей и верность одному партнеру также являются эффективными методами профилактики. Открытое общение с партнером о сексуальном здоровье и истории заболеваний позволяет принимать осознанные решения и снижать риск заражения. В 2026 году активно разрабатываются и внедряются новые методы профилактики, включая вакцины против гонореи, однако их широкое применение пока ограничено. Повышение осведомленности о гонорее, ее симптомах, методах диагностики и профилактики, играет ключевую роль в снижении заболеваемости и защите здоровья населения.
